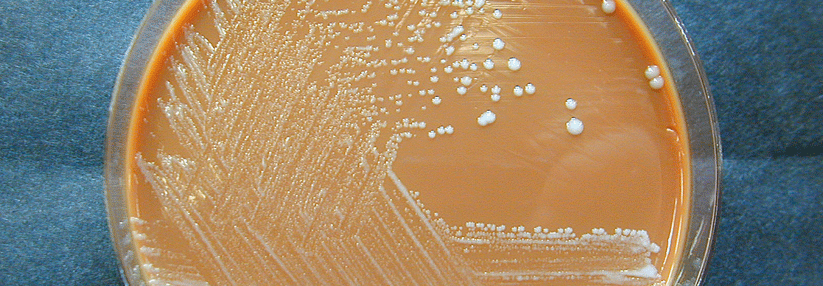

Im Rahmen unserer Website-Modernisierung arbeiten wir kontinuierlich daran, Ihnen noch bessere und aktuellere Informationen zu bieten. Diese Seite wird in Kürze mit frischen Inhalten und einem zeitgemäßen Design überarbeitet.
Tularämie
Tularämie ist eine relativ seltene Zoonose durch Francisella (F.) tularensis, ein gramnegativer intrazellulärer Coccobazilllus. Es gibt die beiden klinisch relevanten Subspecies F. tularensis tularensis (nur in Nordamerika) und F. tularensis holarctica (gesamte nördliche Hemisphäre einschließlich Europa).
F. tularensis hat ein breites Wirtsspektrum. Er infiziert v. a. verschiedene Kleinsäuger wie Hasen, Kaninchen und Mäuse, aber auch andere Wild- und Haustiere. Darüber hinaus wurde er bei blutsaugenden Arthropoden wie Bremsen, Mücken und Zecken, aber auch in Vögeln und Amphibien nachgewiesen. Auch in der Umwelt (Wasser, Erde) kommt der bei niedrigen Temperaturen sehr widerstandfähige Erreger vor.
F. tularensis ist ein hochinfektiöser Erreger – die infektiöse Dosis liegt bei nur ca. 10 Erregern (außer bei Aufnahme über den Magen-Darm-Trakt). Die Infektion kann erfolgen durch:
- Kontakt der Haut oder Schleimhäute mit infektiösem Tiermaterial (z.B. bei der Verarbeitung infizierter Tiere) oder mit kontaminiertem Wasser
- Verzehr von nicht ausreichend erhitztem, kontaminiertem Fleisch (z.B. Hasen) oder anderen kontaminierten Lebensmitteln (z.B. durch Mäusekot kontaminiertes Getreide)
- Aufnahme von kontaminiertem Wasser
- Inhalation von kontaminiertem Staub oder Aerosolen (z.B. beim industriellen Waschen und Zerkleinern von kontaminiertem Gemüse, Rasenmähen oder Heubearbeiten)
- Stich oder Biss von infizierten blutsaugenden Arthropoden (z.B. von Bremsen, Mücken, Zecken).
Eine Mensch-zu-Mensch-Übertragung ist nicht bekannt, aber bei engem Kontakt mit Erkrankten auch nicht sicher auszuschließen.
In Europa werden pro Jahr etwa 500 bis 1000 Fälle gemeldet. Betroffen sind häufig Personen, die sich viel in der freien Natur aufhalten (ländliche Bevölkerung, Jäger und Waldarbeiter).
Die Inkubationszeit beträgt – abhängig von Infektionsdosis, Infektionsweg und Virulenz des Erregerstammes – 1 bis 14 Tage (in der Regel 3 bis 5 Tage).
Neben grippeähnlichen Symptomen (v. a. Fieber, Lymphknotenschwellungen, Schüttelfrost, Unwohlsein sowie Kopf- und Gliederschmerzen) kann das klinische Bild bei Tularämie sehr vielfältig sein. In Abhängigkeit von der Eintrittspforte werden die folgenden Formen unterschieden:
Ulzeroglandulär und glandulär (nach Hautkontakt mit den Erregern, auch ohne vorhandene Wunden oder offene Hautstellen, inklusive Arthropodenbiss/-stich):
- Bildung einer primären Ulzeration (häufig zunächst unentdeckt, Größe von wenigen Millimetern bis wenigen Zentimetern)
- regionale Lymphknotenschwellung (bei spätem Behandlungsbeginn vereiternd und nekrotisierend)
Oculoglandulär (nach Infektion des Auges, z.B. durch Wischen mit der kontaminierten Hand):
- meist einseitige Konjunktivitis mit Ödemen am Lid oder starkem Tränenfluss, Lichtempfindlichkeit
- regionale Lymphknotenschwellung.
Oropharyngeal (nach Aufnahme von kontaminiertem Wasser oder Lebensmitteln):
- meist einseitige, oft massive submandibuläre und zervikale Lymphknotenschwellung
- Stomatitis, Pharyngitis, Tonsillitis möglich
- bei hohen Dosen evtl. gastrointestinale Beteiligung mit Bauchschmerzen, Erbrechen und Durchfall
Pulmonal (nach Inhalation der Erreger):
- Bronchopneumonie, (Husten, Brustschmerzen, Atemstörungen und Atemnot)
- Schweißausbrüche
- Übelkeit, Erbrechen
- hiläre Lymphknotenschwellung
Bei Infektion mit dem Subtyp tularensis können folgende Komplikationen auftreten:
- sekundäre Pneumonie (unbehandelt Letalität 30-60 %)
- schwere Septikämie
- Endokarditis
- Leber- und Nierenversagen
Bei Subtyp hoarctica:
- gelegentlich Meningitis und Sepsis
- Pneumonie sehr selten
Bei beiden Typen: Erythema nodosum und Erythema multiforme
Körperliche Befunde je nach vorherrschender Symptomatik (eher unspezifisch).
Proben für den Erregernachweis sollten, wenn möglich, vor einer antibiotischen Therapie genommen werden. Der direkte Erregernachweis durch Anzucht auf speziellen Nährmedien Nährmedien aus Blut, Gewebeproben (Leber, Milz) oder Abstrichen gelingt nicht immer, sollte aber in jedem Fall versucht werden.
Da Antibiotikaresistenzen beschreiben sind, sollte standardmäßig immer auch eine Resistenztestung der angezüchteten Erreger erfolgen.
Auch ein direkter Erregernachweis mittels PCR ist möglich.
Indirekt kann die Infektion auch durch den Nachweis von Serumantikörpern gegen den Erreger diagnostiziert werden. Ein einmalig hoher Titer oder ein Anstieg des Titers sprechen für eine vorangegangene Infektion.
Die möglichen Differenzialdiagnosen hängen von den unterschiedlichen Manifestationen ab.
Um einen schweren Krankheitsverlauf und Komplikationen zu vermeiden, sollte frühzeitig mit Antibiotika behandelt werden.
Wirksam gegen F. tularensis sind:
- Aminoglycoside
- Fluorchinolone
- Tetracycline
- Chloramphenicol
- Rifampicin
Penicilline und andere Beta-Lactam-Antibiotika sind wirkungslos. Vor Ausschluss von Resistenzen sollte die Behandlung nicht mit Makrolidantibiotika erfolgen.
Meldepflicht:
Namentlich meldepflichtig ist der direkte oder indirekte Nachweis von Francisella tularensis, soweit er auf eine akute Infektion hinweist (innerhalb von 24 Stunden).
Zum Schutz vor Übertragung sollten bei Kontakt mit kranken und toten Wildtieren, (insbesondere Hasen und Kaninchen) Vorsichtsmaßnahmen wie das Tragen von Handschuhen getroffen werden. Bei zu erwartender Aerosolentwicklung sollte eine Atemschutzmaske (FFP2/FFP3) getragen werden.
Fleisch von Hasen und Kaninchen sollte nur gut durchgegart verzehrt werden.
In Gegenden, in denen Fälle von Tularämie aufgetreten sind, muss Oberflächen- und Brunnenwasser vor dem Trinken abgekocht werden. Der Kontakt mit durch Tierkadaver kontaminiertem Wasser sollte grundsätzlich gemieden werden.
Ein Impfstoff ist in Deutschland nicht zugelassen.
Verschenken Sie kein Honorar: Das „Gebühren-Handbuch digital“ ist die ideale Weiterentwicklung der Printausgabe des bekannten „Medical Tribune Gebühren-Handbuchs“ - statt 2000 Buchseiten der schnelle digitale Zugriff.
Was Ihnen die Abrechnung leichter macht:
- die immer aktuelle Fassung von EBM und GOÄ (Einheitlicher Bewertungsmaßstab und Gebührenordnung für Ärzte)
- Tipps und Experten-Kommentare zur Honorarabrechnung (EBM/GOÄ), graphisch aufbereitet und leicht verständlich
- Kommentare von Kollegen lesen und selbst kommentieren
- persönliche Notizen und Lesezeichen setzen
Fortbildungen
Keine Fortbildung für diesen Fachbereich gefunden
Alle FortbildungenDiese Informationen dienen ausschließlich der Aus- und Weiterbildung von Angehörigen und Studenten der medizinischen Fachkreise (z.B. Ärzte) und enthalten nur allgemeine Hinweise. Sie dürfen nicht zur Selbstdiagnose oder -behandlung verwendet werden und sind kein Ersatz für eine ärztliche Beratung oder Behandlung. Die jeweiligen Autoren haben die Inhalte nach bestem Wissen gepflegt. Dennoch sollten Sie die Informationen stets kritisch prüfen und mit zusätzlichen Quellen vergleichen. Die Autoren und die Betreiber von medical-tribune.de übernehmen keine Haftung für Schäden, die durch nicht-kontrollierte Anwendung von Empfehlungen und Inhalten entstehen. Beiträge, die Angaben zum Einsatz und zur Dosierung von Medikamenten machen, sind die persönliche Einschätzung der Autoren. Sie ersetzen nicht die Empfehlungen des Herstellers oder des behandelnden Arztes oder Apothekers.